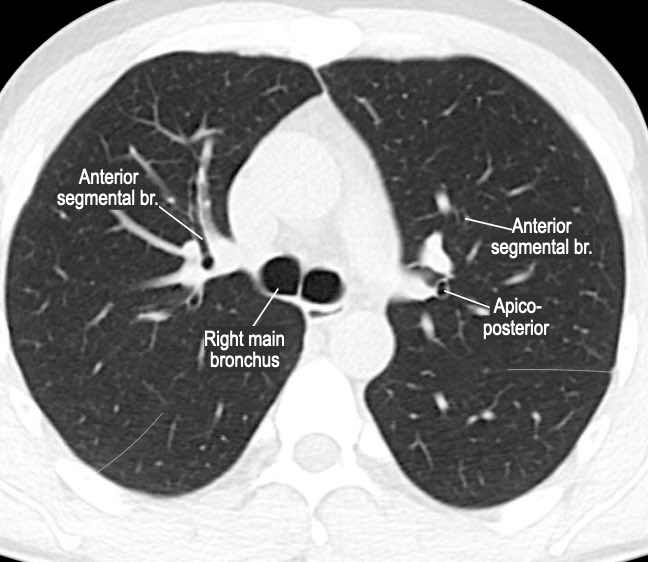
Slider image 5
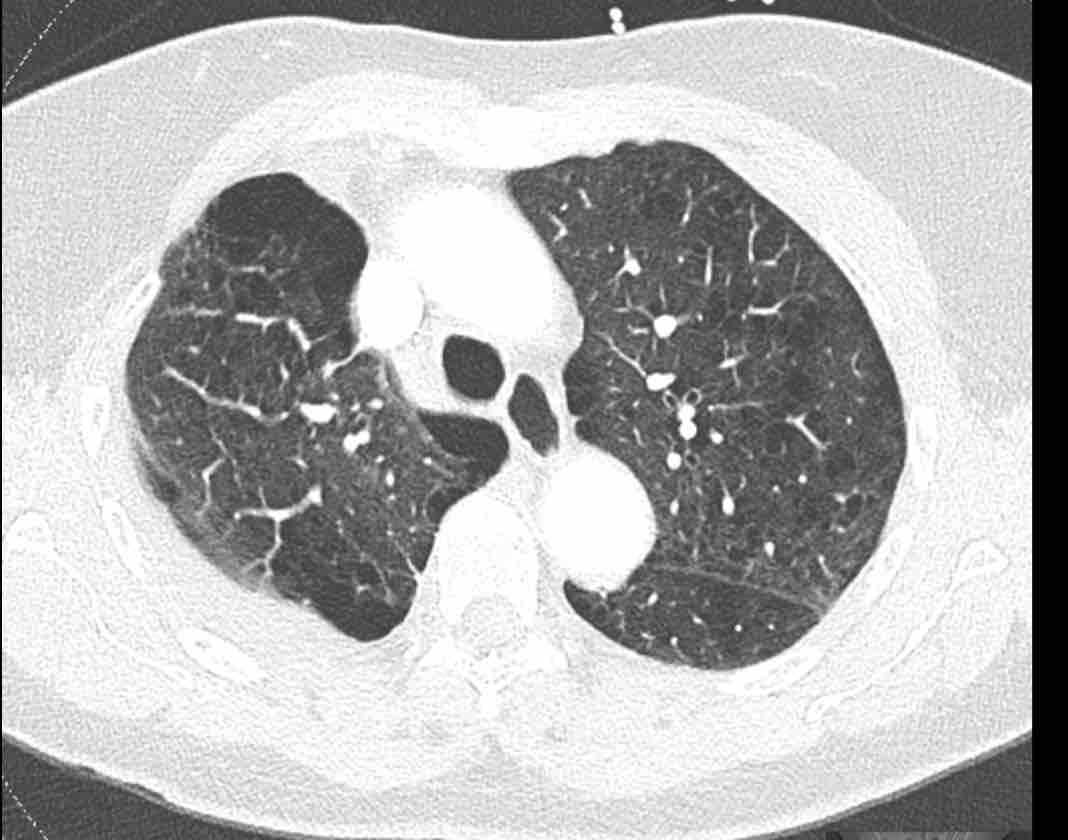
Slider image 2

Phân thùy phổi và phế quản
Sự am hiểu của bác sĩ chẩn đoán hình ảnh về các phân chia giải phẫu của phổi là điều thiết yếu trong nhiều khía cạnh của thực hành lâm sàng, vì điều này có thể giúp phát hiện các bất thường dễ dàng hơn, định vị bệnh lý chính xác hơn, đồng thời hỗ trợ trong việc trao đổi thông tin với các phẫu thuật viên, bác sĩ hô hấp và các thành viên khác trong nhóm đa chuyên khoa.
Trước tiên, chúng tôi sẽ mô tả giải phẫu phổi kèm theo các hình minh họa và hình ảnh CT có thể cuộn xem.
Tiếp theo, chúng tôi sẽ trình bày một số ca lâm sàng để minh họa giá trị gia tăng của việc nắm vững kiến thức về giải phẫu phân thùy phổi.
Giải phẫu
Các phân thùy phổi – hình minh họa
Thùy trên phổi phải (màu xanh lam)
Phân thùy đỉnh (RB1) – Phân thùy sau (RB2) – Phân thùy trước (RB3)
Thùy giữa (màu xanh lá)
Phân thùy bên (RB4) – Phân thùy trong (RB5)
Thùy dưới phổi phải (màu cam)
Phân thùy trên (RB6) – Phân thùy đáy trong (RB7) – Phân thùy đáy trước (RB8) – Phân thùy đáy bên (RB9) – Phân thùy đáy sau (RB10).
Phân thùy trên và phân thùy đáy trong của thùy dưới phổi phải không
hiển thị trong hình minh họa này do chúng nằm ở phía sau so với thùy trên
và thùy giữa phổi phải.
Thùy trên phổi trái (màu xanh lam)
Phân thùy đỉnh-sau (LB1/2) – Phân thùy trước (LB3)
Lưỡi phổi (màu xanh lá)
Phân thùy trên (LB4) – Phân thùy dưới (LB5)
Thùy dưới phổi trái (màu cam)
Phân thùy trên (LB6) – Phân thùy đáy trước (LB8) – Phân thùy đáy bên (LB9) – Phân thùy đáy sau (LB10).
Phân thùy trên của thùy dưới phổi trái không hiển thị trong hình minh họa này
do nó nằm ở phía sau so với thùy trên phổi trái.

Danh sách tất cả các phân thùy phổi. Trong ngoặc là số thứ tự theo phân loại Boyden, thường được các phẫu thuật viên và bác sĩ hô hấp sử dụng. Lưu ý rằng phân thùy 7 không có ở phổi trái.
Giải phẫu phân thùy của hai phổi có tính đối xứng nhất định, vì phổi trái chỉ khác phổi phải một chút.
Phổi phải có ba thùy (gồm thùy trên, thùy giữa và thùy dưới) với mười phân thùy,
trong khi phổi trái có hai thùy (gồm thùy trên và thùy dưới) với số phân thùy ít hơn.
Ở
thùy trên phổi trái, phân thùy đỉnh và phân thùy sau có chung một thân phế quản phân thùy
và được gộp lại thành phân thùy đỉnh-sau.
Lưỡi phổi là một phần của thùy trên phổi trái và có hướng trên/dưới, trong khi
thùy giữa ở phổi phải tách biệt với thùy trên và có hướng trong/ngoài.
Ở thùy dưới phổi trái có
phân thùy đáy trước, nhưng không có phân thùy đáy trong riêng biệt (LB7) do vị trí
của tim ở bên trái trong khoang ngực.
Cần lưu ý rằng các tài liệu chẩn đoán hình ảnh
và phẫu thuật có thể có sự khác biệt nhất định về tên gọi các phân thùy bên trái,
với một số bài báo đề cập đến phân thùy đáy trước-trong (LB7/8)
ở thùy dưới phổi trái.
Ngoài ra, phân thùy đỉnh-sau của thùy trên phổi trái
đôi khi được coi là hai phân thùy riêng biệt chỉ có chung một thân phế quản.
Cây phế quản
Từ khí quản và phế quản chính, đường thở tiếp tục phân chia thành các phế quản thùy (hay phế quản bậc hai), sau đó thành các phế quản phân thùy (hay phế quản bậc ba).
Các phân thùy phổi được xác định dựa trên thế hệ phế quản này.
Phân thùy phổi là một đơn vị chức năng độc lập của phổi, được cung cấp bởi phế quản phân thùy và động mạch phổi riêng, đồng thời có hệ thống dẫn lưu tĩnh mạch và bạch huyết riêng.
Điều này cho phép cắt bỏ một phân thùy mà không ảnh hưởng đến các phân thùy lân cận.
Các phẫu thuật viên ứng dụng kiến thức này trong việc lập kế hoạch và thực hiện phẫu thuật cắt phân thùy phổi – một phương pháp ngày càng được ưu tiên hơn so với cắt thùy phổi đối với các tổn thương nhỏ ở ngoại vi không có xâm lấn hạch bạch huyết, vì người ta cho rằng việc bảo tồn mô phổi sẽ cải thiện chức năng hô hấp sau phẫu thuật mà không ảnh hưởng đến nguyên tắc điều trị ung thư.
Phế quản trên CT
Cuộn qua các hình ảnh để quan sát khí quản phân chia thành phế quản chính phải và trái, sau đó tiếp tục phân chia thành các phế quản thùy và phế quản phân thùy.
Các phân thùy phổi trên CT
Cuộn qua các hình ảnh để quan sát cách phổi được phân chia thành các phân thùy.
Các biến thể phế quản bẩm sinh
Có một số biến thể trong các kiểu phân nhánh phế quản thường gặp.
Để phát hiện các bất thường, việc nắm vững một số nguyên tắc giải phẫu là điều thiết yếu, đặc biệt là kiểu phân nhánh phân thùy kinh điển như đã mô tả ở trên.
Phế quản khí quản và phế quản tim phụ là những biến thể đường thở khá nổi bật, tuy nhiên các biến thể nhỏ hơn và ít rõ ràng hơn trong cả giải phẫu đường thở lẫn mạch máu cũng xuất hiện ở cấp độ (dưới) phân thùy.
Thùy tĩnh mạch azygos
Một biến thể rất thường gặp trong giải phẫu phổi là thùy azygos, trong đó có một rãnh liên thùy phụ, có hoặc không có tĩnh mạch azygos đi qua rãnh này.
Các rãnh liên thùy phụ ở các vị trí khác cũng như các rãnh liên thùy không hoàn toàn cũng là những phát hiện thường gặp và hầu như không có ý nghĩa lâm sàng.
Hình ảnh
Thùy azygos ở nam giới 74 tuổi với tĩnh mạch azygos ở vị trí bình thường (mũi tên vàng).
Đây là một trường hợp khác, trong đó tĩnh mạch azygos đi qua rãnh liên thùy azygos (đầu mũi tên).
Phế quản khí quản
Trong biến thể phế quản khí quản, thùy trên phổi phải được thông khí một phần bởi một phế quản xuất phát trực tiếp từ khí quản phía trên carina.
Hình ảnh
Phế quản khí quản phát hiện tình cờ ở nam giới 28 tuổi được chụp CT theo dõi ung thư (hình ảnh mặt cắt ngang), và ở nam giới 2 tuổi được chụp CT vì nhiễm trùng tái phát (hình ảnh mặt cắt vành).
Phế quản tim
Phế quản tim là một phế quản thừa thực sự, xuất phát đối diện với lỗ vào thùy trên phổi phải ở mặt trong của phế quản trung gian. Nó có thể thông khí cho một phần nhỏ nhu mô phổi, hoặc có thể là một cấu trúc tận cùng mù.
Bệnh nhân thường không có triệu chứng, mặc dù có thể xảy ra nhiễm trùng tái phát do thanh thải chất nhầy không đầy đủ.
Hình ảnh
Phế quản tim ở nữ giới 57 tuổi đang theo dõi bệnh phổi kẽ.
Dị vị tạng
Một biến thể hiếm gặp xảy ra trong hội chứng dị vị tạng, trong đó có sự định hướng bất thường trái-phải của các cơ quan, không phải là vị trí tạng bình thường (situs solitus) cũng không phải là đảo ngược hoàn toàn (situs inversus).
Trong bối cảnh này, đồng phân (isomerism) mô tả giải phẫu đối xứng gương, trong đó ở đồng phân phải hoặc trái, giải phẫu phế quản tương tự nhau ở cả hai bên.
Dị vị tạng thường liên quan đến các bất thường tim bẩm sinh và các dị tật phát triển khác.
Hình ảnh
Hình ảnh MinIP (chiếu cường độ tối thiểu) lát dày trong đồng phân trái ở nữ giới 54 tuổi mắc bệnh tim bẩm sinh, cho thấy giải phẫu phế quản đối xứng với hình ảnh ‘hai phổi trái’.
Teo phế quản
Sự gián đoạn của cây phế quản cũng có thể xảy ra, như trong trường hợp teo phế quản, trong đó một đoạn phế quản gần bị tắc nghẽn.
Teo phế quản có thể được phát hiện tình cờ, hoặc có thể liên quan đến các triệu chứng ho, khó thở và đôi khi nhiễm trùng tái phát.
Hình ảnh học điển hình cho thấy một cấu trúc phân nhánh với nhu mô phổi sáng xung quanh, đại diện cho một phế quản giãn rộng chứa đầy chất nhầy không thông với cây phế quản, kèm theo ứ khí phổi liên quan.
Hình ảnh
Teo phế quản ở thùy dưới phổi trái ở nữ giới 47 tuổi.
Cấu trúc phân nhánh điển hình với nhu mô phổi sáng xung quanh, đại diện cho phế quản giãn rộng chứa đầy chất nhầy (mũi tên).
Không có lỗ vào của phế quản phân thùy đáy sau (LB10) và ứ khí lan rộng của nhu mô phổi liên quan, thấy rõ nhất trên các tái tạo phổi.
Tiếp tục với hình ảnh tiếp theo…
Hình ảnh MIP (chiếu cường độ tối đa) lát dày cho thấy các đường thở giãn rộng chứa đầy chất nhầy ở thùy dưới phổi trái (mũi tên).
Thay đổi do can thiệp y tế
Phẫu thuật cắt bỏ
Các phẫu thuật viên, bác sĩ nội soi phế quản và bác sĩ xạ trị đều có thể làm thay đổi giải phẫu của phổi.
Việc theo dõi đường đi của các phế quản từ khí quản đến mức phân đoạn trên CT sẽ giúp tránh bỏ sót những thay đổi không được đề cập trong thông tin lâm sàng, hoặc xác định chính xác phần phổi nào đang có bệnh lý.
Kiến thức về giải phẫu phế quản bình thường là chìa khóa để xác định phần nào đã được cắt bỏ, đã được điều trị hoặc đang bị di lệch.
Cắt thùy và cắt phân thùy phổi
Để cắt bỏ các tổn thương khu trú, phẫu thuật viên có thể lựa chọn giữa cắt hình nêm không theo giải phẫu, cắt phân thùy theo giải phẫu, cắt (một hoặc hai) thùy phổi hoặc cắt toàn bộ một phổi.
Theo dõi đường đi của các phế quản đến đường khâu ghim sẽ giúp xác định phương pháp phẫu thuật đã thực hiện và phần phổi đã được cắt bỏ.
Trong tình trạng sau phẫu thuật, mô phổi còn lại sẽ lấp đầy khoang ngực cùng bên, có thể bị căng phồng quá mức và di lệch. Ngoài ra, trong quá trình này có thể xảy ra hiện tượng trung thất bị đẩy lệch và tràn dịch màng phổi.
Việc theo dõi các phế quản còn hiện diện sẽ giúp xác định chính xác mô phổi bị di lệch.
Hình ảnh
Cuộn qua các hình ảnh.
Phế quản thùy trên, phế quản trung gian và phế quản thùy dưới tiếp tục đi về phía ngoại vi.
Phế quản thùy giữa kết thúc tại vị trí đặt các ghim phẫu thuật.
Xoắn phổi
Việc theo dõi đường đi của các phế quản sẽ giúp xác định mô phổi bị di lệch.
Các hình ảnh này của một bệnh nhân nữ 65 tuổi sau khi đã cắt thùy trên phổi phải trước đó.
Trước tiên, hãy cuộn qua các hình ảnh.
Hình ảnh
Theo dõi lần lượt các phế quản giúp xác định mỏm cắt thùy trên phổi phải (RUL), phế quản thùy giữa bị tắc nghẽn và các phế quản thùy dưới còn thông.
Điều này xác định mô phổi bị di lệch xuống dưới chính là thùy giữa phổi phải (RML), thấy rõ nhất trên mặt phẳng đứng dọc.
Thùy giữa phổi phải bị phù nề và không còn được tưới máu.
Ngoài ra còn thấy hình ảnh ứ máu và xẹp phổi ở các phân thùy đáy của thùy dưới phổi phải (RLL), hiện nằm phía trên thùy giữa phổi phải đã bị nhồi máu.
Thiếu máu cục bộ phân thùy phổi
Thiếu máu cục bộ cũng có thể xảy ra sau phẫu thuật cắt phân thùy, khi lưu lượng máu đến các phân thùy còn lại không đủ do bị chèn ép, gập góc hoặc các nguyên nhân khác.
Với số lượng phẫu thuật cắt phân thùy dự kiến sẽ tăng lên trong những năm tới, đây là một biến chứng có thể sẽ được gặp thường xuyên hơn.
Do đó, việc làm quen với thực thể bệnh lý này là rất quan trọng.
Hình ảnh
Cuộn qua các hình ảnh.
Theo dõi các phế quản của thùy dưới phổi trái cho thấy nhánh phân thùy đầu tiên của thùy dưới phổi trái còn thông; đó là phế quản phân thùy đỉnh.
Các ghim phẫu thuật nằm tại vị trí của các phân thùy đáy sau và đáy bên (LB9/10), vốn thường được cắt bỏ cùng nhau.
Do đó, phân thùy phổi có hình ảnh kính mờ và đông đặc phải là phân thùy đáy trước của thùy dưới phổi trái (LB8).
Động mạch phổi đến phân thùy này cũng không ngấm thuốc cản quang, và bản đồ tưới máu iốt nhấn mạnh thêm tình trạng nhồi máu.
Bệnh nhân đã được phẫu thuật lại và tiến hành cắt bỏ phân thùy bị nhồi máu, với xác nhận qua giải phẫu bệnh.
Tiếp tục với bản đồ tưới máu…
Trên bản đồ tưới máu iốt, có sự tưới máu ở thùy trên phổi trái và phân thùy đỉnh của thùy dưới phổi trái, nhưng không có sự tưới máu ở phân thùy đáy trước của thùy dưới phổi trái.
Van nội phế quản
Một thủ thuật tương đối mới để điều trị bệnh nhân khí phế thũng nặng là giảm thể tích phổi qua nội soi (ELVR).
ELVR là một hình thức giảm thể tích phổi không phẫu thuật.
Các van nội phế quản một chiều được đặt vào các phế quản phân thùy của thùy phổi bị tổn thương nặng nhất.
Các van nội phế quản này dần dần làm xẹp phần phổi được điều trị và cho phép phần còn lại của phổi hoạt động hiệu quả hơn.
Hình ảnh
Van nội phế quản trong các phế quản phân thùy đáy của thùy dưới phổi phải sau khi giảm thể tích phổi qua nội soi.
Lưu ý rằng thủ thuật không tạo ra được tình trạng xẹp thùy phổi như mong muốn, với tình trạng căng phồng quá mức của thùy dưới vẫn còn hiện diện (đầu mũi tên).
Điều này được cho là do hiện tượng thông khí bàng hệ.
Hóa xạ trị
Điều trị ung thư có thể gây ra tình trạng biến dạng cấu trúc đáng kể, gây khó khăn cho việc định hướng giải phẫu.
Việc theo dõi đường đi của các phế quản giúp dễ dàng xác định giải phẫu phổi sau điều trị hơn.
Bằng cách đó, có thể tránh được sự nhầm lẫn và mâu thuẫn giữa các báo cáo chẩn đoán hình ảnh.
Hình ảnh
Những thay đổi cấu trúc lan rộng ở nửa ngực phải sau hóa xạ trị cho ung thư phổi không tế bào nhỏ (NSCLC) giai đoạn 4.
Theo dõi đường đi của các phế quản cho thấy thùy trên phổi phải phần lớn còn thông khí, trong khi
Bệnh huyết khối tắc mạch
Các động mạch phổi đi kèm với các phế quản trên đường đến ngoại vi, do đó có các nhánh thùy, phân thùy và dưới phân thùy.
Có thể phân biệt bằng cách truy theo các nhánh động mạch tương ứng với các phế quản.
Trong thuyên tắc phổi (PE) cấp tính, điều quan trọng chủ yếu là phân biệt chính xác huyết khối phân thùy với huyết khối dưới phân thùy, vì điều trị chống đông trong PE dưới phân thùy đơn độc vẫn còn đang được tranh luận.
Hình ảnh
Đây là các hình ảnh của bệnh nhân nữ 59 tuổi tại khoa cấp cứu,
minh họa rõ ràng các huyết khối ở các mức độ khác nhau.
Cuộn qua các hình ảnh.
- Huyết khối trong động mạch thùy đến thùy trên phổi phải.
- Huyết khối tại lỗ vào của động mạch phân thùy đáy sau của thùy dưới phổi phải.
- Huyết khối dưới phân thùy ở phân thùy đáy trước của thùy dưới phổi phải, vài nhánh phía sau động mạch phân thùy.
- Huyết khối tại chỗ phân đôi phân thùy của thùy trên phổi trái.
- Huyết khối tiếp tục lan về phía ngoại vi trong động mạch dưới phân thùy.
Tăng áp động mạch phổi do huyết khối tắc mạch mạn tính
Việc xác định vị trí giải phẫu chính xác trong PE mạn tính là rất quan trọng, vì các lựa chọn điều trị can thiệp đối với huyết khối mạn tính ở bệnh nhân tăng áp động mạch phổi (CTEPH) phụ thuộc nhiều vào vị trí giải phẫu.
Phẫu thuật nội mạc động mạch phổi nhắm vào các huyết khối trung tâm, đến mức phân thùy.
Tạo hình mạch phổi bằng bóng nhắm vào các tổn thương xa hơn.
Thông thường, huyết khối mạn tính biểu hiện dưới dạng huyết khối bám thành mạch, màng ngăn (web) hoặc thay đổi khẩu kính động mạch đột ngột do tăng sinh và tiêu hủy một phần các huyết khối trước đó.
Điều này trái ngược với bệnh huyết khối tắc mạch cấp tính, thường biểu hiện dưới dạng các dải huyết khối tắc mạch tại chỗ phân nhánh mạch máu hoặc huyết khối gây tắc nghẽn nhưng vẫn bảo tồn khẩu kính động mạch.
Hình ảnh
Huyết khối bám thành trong động mạch phổi chính trái ở bệnh nhân mắc bệnh huyết khối tắc mạch mạn tính.
Hình ảnh MIP lát dày của bệnh nhân nam 70 tuổi mắc bệnh huyết khối tắc mạch mạn tính kèm tăng áp động mạch phổi (CTEPH).
Hình ảnh
Có huyết khối phân thùy tắc nghẽn cấp tính trên nền mạn tính ở phân thùy trước của thùy trên phổi trái
(mũi tên đen).
Tắc nghẽn phân thùy có sẵn ở các nhánh đáy với hẹp đột ngột của các mạch máu ngoại vi (mũi tên xanh).
Đây là các hình ảnh của bệnh nhân nam 53 tuổi
mắc tăng áp động mạch phổi.
Hình ảnh
- Màng ngăn (web) phân thùy hai bên (mũi tên đen)
- Màng ngăn phân thùy kèm hẹp đột ngột động mạch dưới phân thùy ở phía xa (mũi tên vàng).
- Hình ảnh MIP cho thấy màng ngăn phân thùy hai bên kèm hẹp đột ngột động mạch dưới phân thùy ở phía xa (đầu mũi tên)
Kết luận
Màng ngăn phân thùy hai bên, kèm hẹp đột ngột động mạch dưới phân thùy ở phía xa,
phù hợp với tăng áp động mạch phổi do huyết khối tắc mạch mạn tính (CTEPH).
Từ thiện
Toàn bộ lợi nhuận từ Radiology Assistant được dành cho tổ chức Medical Action Myanmar, do Bác sĩ Nini Tun và Giáo sư Frank Smithuis điều hành – ông là giáo sư tại Đại học Oxford và cũng là anh trai của Robin Smithuis.
Nhấn vào đây để xem video về Medical Action Myanmar và nếu bạn thấy Radiology Assistant hữu ích, xin hãy ủng hộ Medical Action Myanmar bằng một món quà nhỏ.